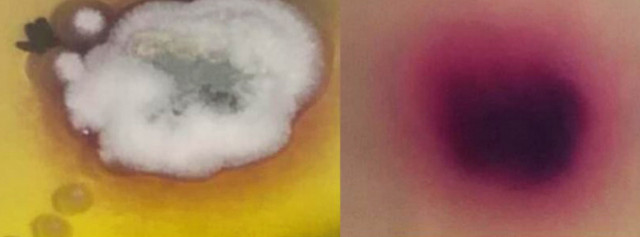
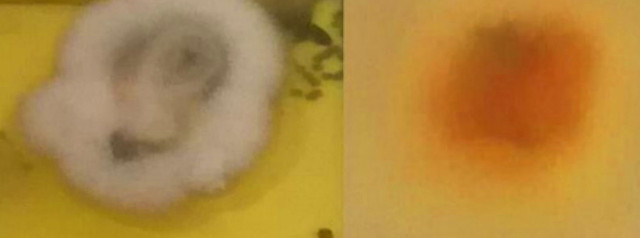

Дерматологические тесты для животных
Описание товара
Дерматологические тесты для животных
Быстрый, простой и удобный анализ, с помощью которого ветеринары, не являющиеся специалистами по микологии, могут подтвердить диагноз дерматофитных инфекций.
Достоинства:
Простой: среда содержит цветовой индикатор, изменяющий цвет в зависимости от того, какие дерматофиты присутствуют в пробе.
Фактический: не требует дополнительной подготовки.
Надежный: индикатор изменяет цвет для визуального и точного диагноза, обеспечивая большую уверенность в диагностическом решении. Результат – в течение 48-72 часа.
Качественный: защищен от загрязнений и обогащен специфическим питательным веществом, что способствует росту спор дерматофитов.
Основными грибами, ответственными за дерматомикоз у домашних животных являются Microsporum canis, М. gypseum и Trichophyton mentagrophytes.
Применение
Тест-среда предназначена для использования в качестве дифференциальной диагностики дерматологических заболеваний у собак, кошек, кроликов и лошадей.
Методы диагностики
Есть разные способы и процедуры для диагностики дерматофитов, но, выращивание грибковой культуры является более обычным, чётким и экономически действенным средством диагностики.
Тест-среда включает в себя:
- Специальные питательные вещества, способствующие росту дерматофитов.
- Специальные препараты, угнетающие рост непатогенных сапрофитных грибков и бактерий.
- Специальный индикатор, изменяющий цвет в зависимости от вида дерматофитов.
Условия хранения и срок годности
В зависимости от температуры хранения от +2 до +8°С, среда пригодна в течение 3 - 6 месяцев. Замораживание и размораживание уничтожает среду.
Процедура проведения теста
- Проверьте места отбора образцов, чтобы убедиться, что они не были обработаны лекарственными средствами, которые могли бы повлиять на результаты.
- Бактериальные или сапрофитные контаминантные области, из которых берут пробу, можно уменьшить путем мягкой очистки с использованием 70% спирта.
- Используя стерильное лезвие скальпеля, возьмите соскреб/или волосы с границы пораженного участка.
- Кошки часто бывают бессимптомными носителями дерматофитий, которые могут заразить других кошек или человека.
- Для проверки таких животных на наличие дерматофитов, используйте новую (или стерилизованную) зубную щетку, чтобы прочесать все тело или в подозреваемых областях и полученные волосы поместите на культуральную среду.
- Поместите образец на культуральную среду и слегка прижмите.
- Закройте чашку или флакон и оставьте их в темном месте в течение испытательного периода при комнатной температуре (22-25°С).
- Ежедневно проверяйте образец изменения цвета среды и процесс роста колоний.
Интерпретация результатов
Статистически положительный результат будет виден примерно через 48-72 часа. Однако в зависимости от различных факторов, в том числе от вида микроорганизмов, количества дерматофитного материала пробы и стадии заболевания может потребоваться более длительный период инкубации
Макроскопические особенности основных дерматологических колоний
Tricophyton mentagrophytes - Зернистая, рассыпчатая, рыхлая и хлопчатобумажная, белого цвета, затем желтая и розового цвета.

Обратная сторона: серо-зеленый.
Microsporum gypseum - Порошковидная с бахромистыми границами коричного цвета.
Microsporum canis - Пушистая, белая и желтая на границе.
Обратная сторона: малиново-красная.
Epidermophyton floccosum - Нежно белая затем бархатная, со временем серая.
Обратная сторона: желтая или темно-желтая.
Оплата и доставка
- Новая Почта
- Самовывоз
- Онлайн оплата
- Наложенный платеж
- Наличный расчёт
- Безналичный расчёт



